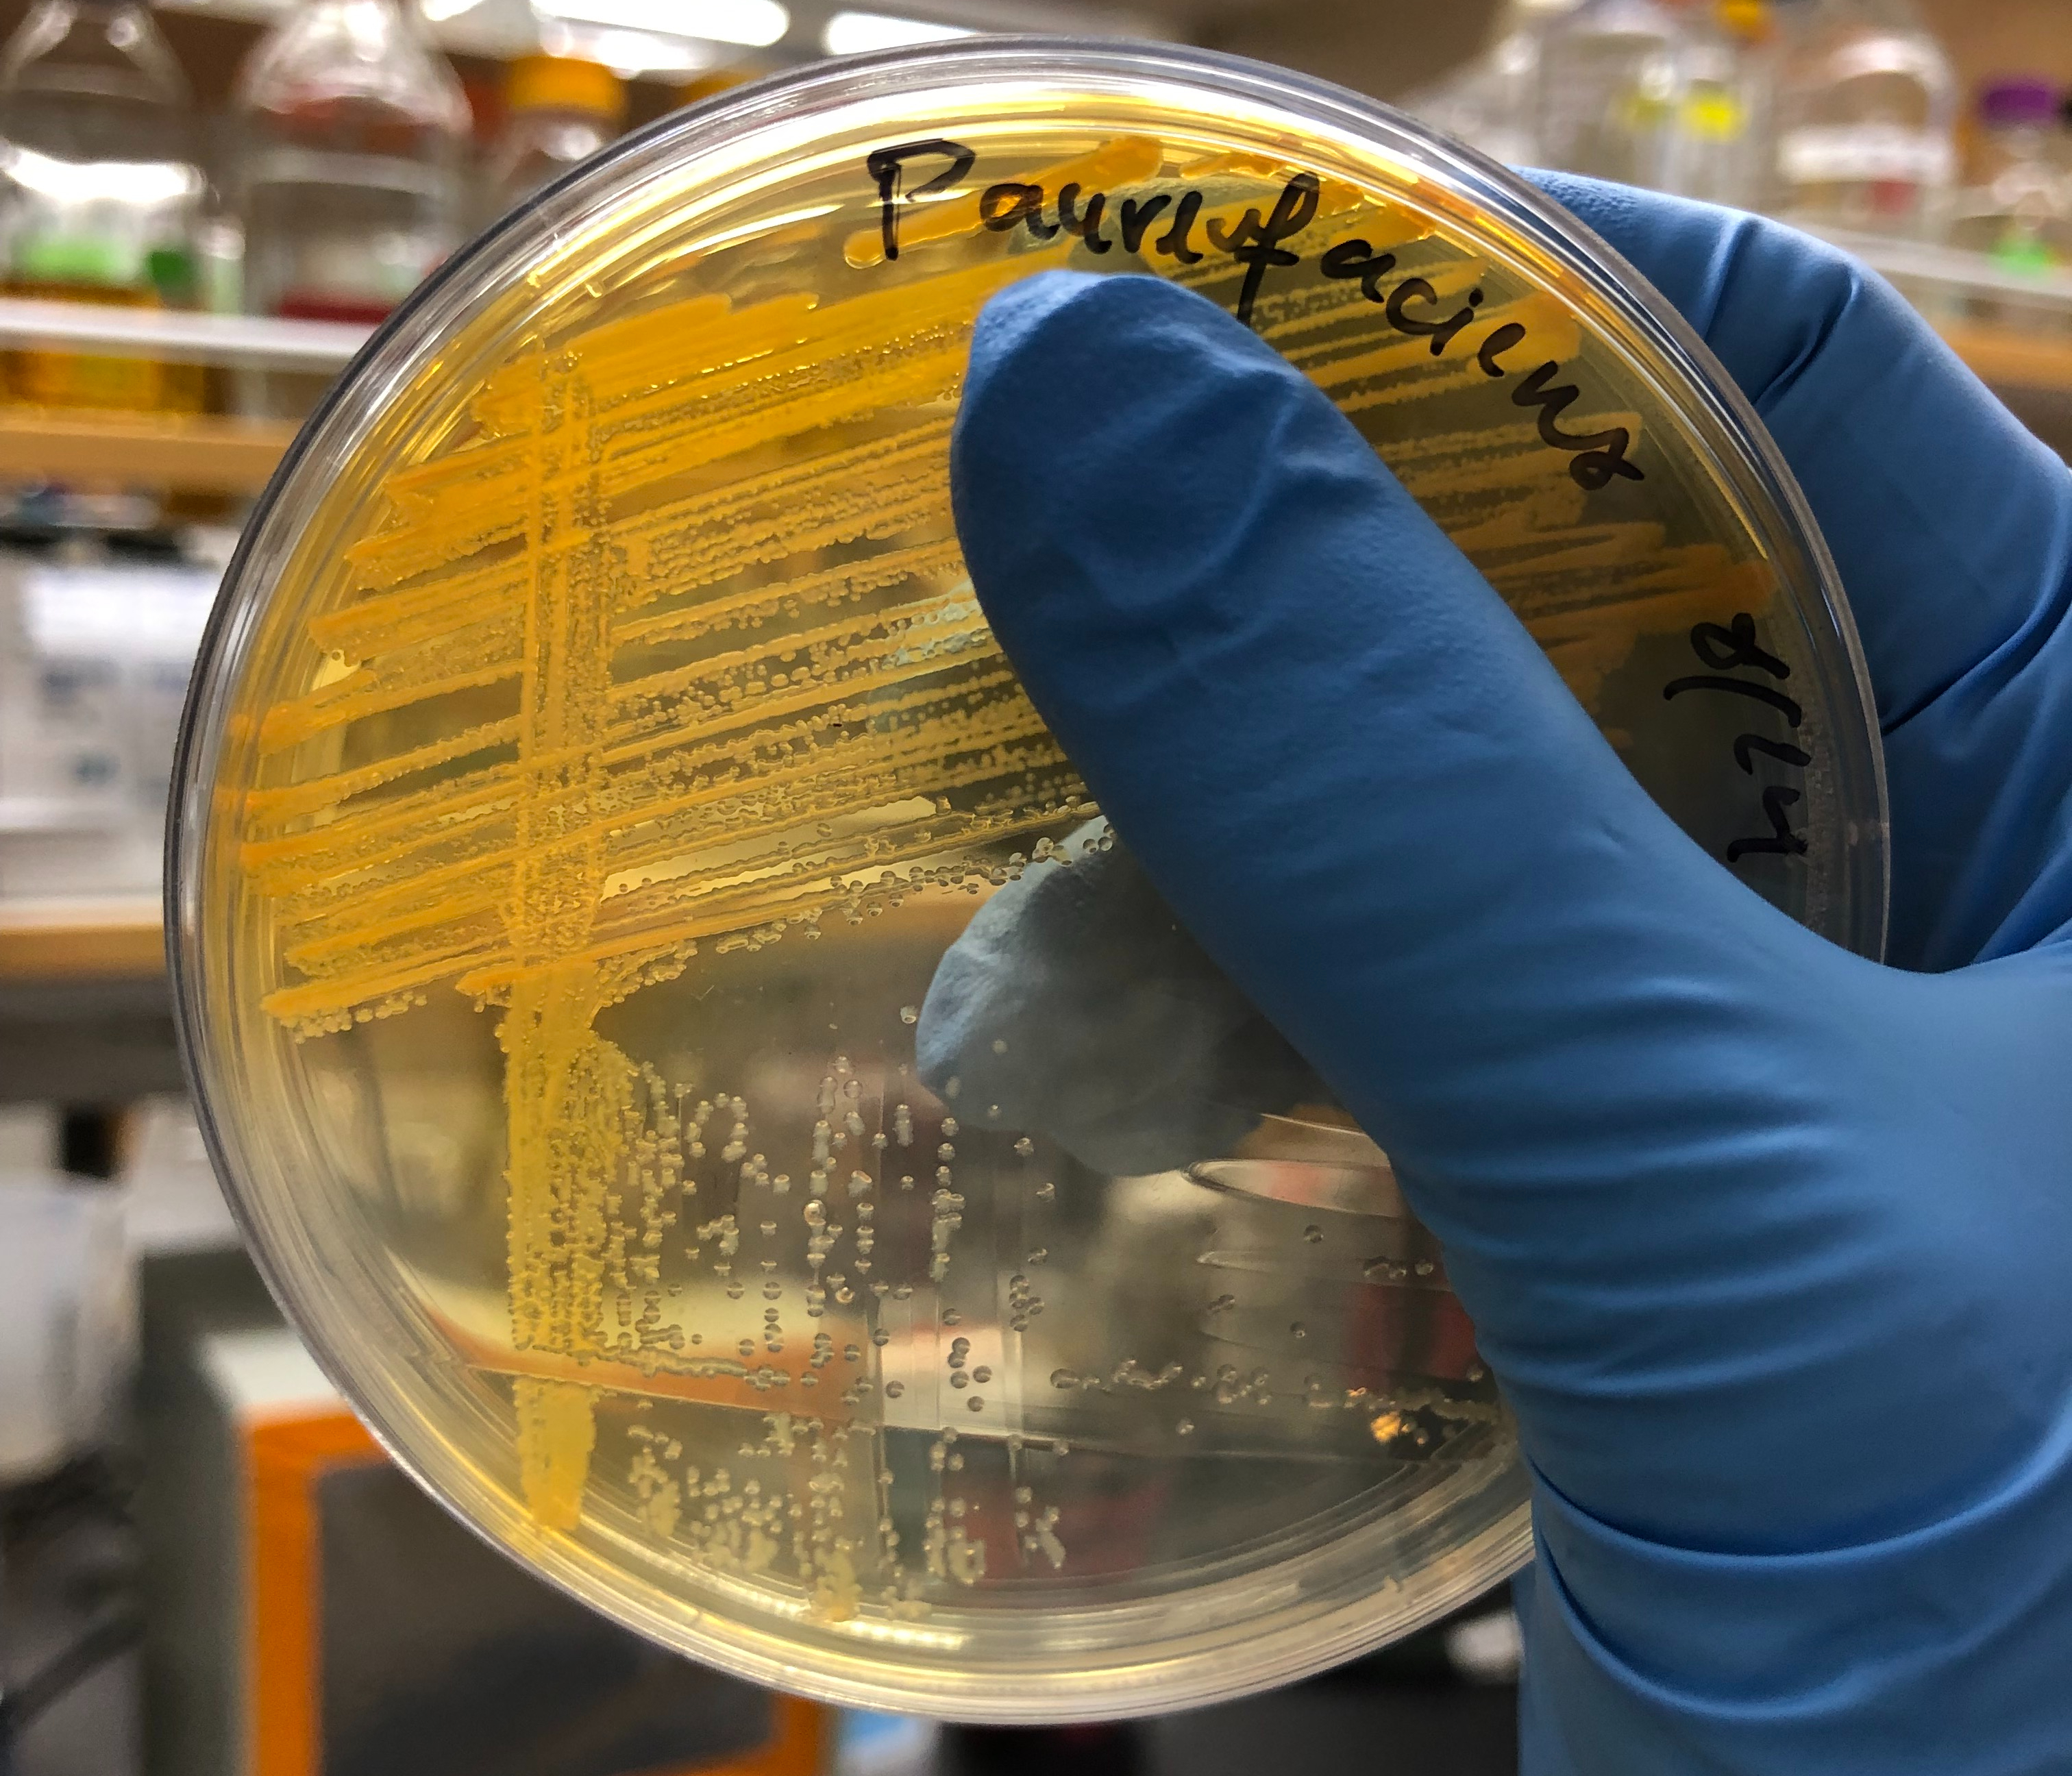

Our research group is interested in understanding how small scale microbially-mediated chemical transformations in soils and sediments affect biogeochemistry and plant growth. We focus specifically on the chemical tools or “secondary metabolites” that microbes (and plants) use to navigate and alter their environment. While we have learned a great deal about the antibiotic properties of secondary metabolites and their utility in human health, we know significantly less about secondary metabolite function in natural contexts. This knowledge gap creates a unique opportunity: secondary metabolites are highly tractable study targets and while they do not encompass the whole of soil and sediment complexity, they epitomize many crucial aspects. We are particularly interested in secondary metabolites that are redox active and/or bind metals as these chemical properties can contribute to weathering and nutrient turnover in natural contexts. Our work incorporates bacterial genetics, genomics, and physiology as well as mass spectrometry and other geochemical measurements. Carbon storage in natural systems and agricultural sustainability are two of the ultimate motivations for our work. Specific projects investigating macronutrient cycling via secondary metabolites are described below.
Role of redox-active metabolites in phosphorus solubilization

Phosphorus (P) is a macronutrient needed by all life on Earth that is also essential for agriculture. We are exploring the use of Redox-Active Metabolites (RAMs) as a microbial strategy to acquire mineral adsorbed phosphorus (via the reductive dissolution of iron oxides). To this end, we are interested in understanding the genetic regulation of secondary metabolite production by phosphorus limitation in model microbes, the production of phosphorus-regulated secondary metabolites by microbes isolated from soils and sediments, and the production of secondary metabolites across phosphorus gradients. For more background please see our recent publications here and here. You can also read about work supported by MIT’s J-WAFS here and by JGI here.

Effect of plant metabolites on carbon and iron cycling
Plants release large amounts of fixed carbon into the rhizosphere in the form of soluble organic carbon exudates. These exudates contain a variety of small molecules including many secondary metabolites that affect the bioavailability of metals, especially the essential trace element iron. We are broadly interested in understanding how metal solubilizing plant metabolites like coumarins and phytosiderophores affect microbial carbon and iron cycling in the rhizosphere. For more information please see our recent publication here.
Microbial N2O production
The climate-active gas nitrous oxide (N2O) is produced by the coupled microbial process of nitrification and denitrification. We are interested in understanding the basic physiology behind N2O production by both groups of organisms and how interactions between nitrifiers and denitrifiers affect the release of N2O. A number of plant metabolites have also been shown to suppress nitrification. We are interested in understanding the molecular mechanisms behind nitrification inhibitors, their effects on microbial communities, and the extent to which they limit the release of N2O in natural and managed systems. You can read about our work supported by the MIT Climate and Sustainability Consortium here.
